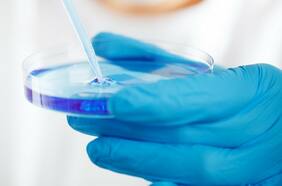
Más de 3.000 científicos de 265 países identifican 13 genes que pueden predecir si padecerá una forma grave de Covid

pulmón
04 FEBRERO
Aunque el tabaquismo sigue siendo la principal causa de cáncer de pulmón, un nuevo estudio revela un factor de riesgo inesperado que está causando cáncer incluso a quienes nunca han fumado, posicionándolo en la quinta causa principal de muerte por cáncer en todo el mundo.
Aumentan casos de cáncer de pulmón en personas que nunca han fumado y un estudio descubre por qué
05 AGOSTO
Los tumores en esta zona del país poseen características diferentes. En América Latina, más del 80% de los casos de cáncer de pulmón se detectan en etapas avanzadas y, en Chile, es la primera causa de muerte dentro de las patologías oncológicas.
“Los tumores de pacientes en Antofagasta son diferentes a cualquier parte del mundo”: el plan para la detección precoz del cáncer de pulmón en la Segunda Región
31 JULIO
05 FEBRERO
Factores ambientales, de hábitos, e incluso de la situación sanitaria en cada región hace que los distintos tipos de cáncer incidan de distintas formas en el país. A continuación un breve repaso por las más presentes, más letales, y las que aumentan con mayor preocupación en la actualidad.
Cáncer en Chile: ¿Cuáles son los que más afectan y en qué regiones son más letales?
28 NOVIEMBRE
04 SEPTIEMBRE
20 JUNIO
Investigación del Instituto Milenio de Física Subatómica en la Frontera de Altas Energía, analizó su presencia en el norte y centro de Chile, el que en altas concentraciones puede producir cáncer de pulmón.
Radiactivo, incoloro e inodoro: estudio mide zonas con mayor presencia del letal gas radón en Chile
04 MAYO
El Dr. Miguel Antúnez, de la Sociedad Chilena de Enfermedades Respiratorias, participó en un nuevo estudio que muestra los cambios que se deben hacer al tratamiento del asma. Una iniciativa global que ya lleva más de tres años incorporándose en diferentes países.
Inhalador azul: piden terminar su uso en Chile por estudios que muestran poca eficacia para tratar asma
13 ENERO
De acuerdo a la Sociedad Americana del Cáncer de ese país, si la tasa de mortalidad se hubiera mantenido estable desde 1991 en lugar de disminuir, casi 3,5 millones más de pacientes con cáncer habrían muerto en el período de 28 años.
La tasa de mortalidad por cáncer cae 32% en EE.UU. desde un peak en 1991
03 AGOSTO
La radiografía del paciente se ve casi completamente blanca, lo que se conoce como opacidad pulmonar. Mientras que en pacientes con la vacuna, se observa una gran cantidad de espacio negro, lo que muestra que pudieron inhalar una cantidad de oxígeno en su mayoría saludable.
Radiografía muestran cómo pulmones de persona no vacunada infectada con Covid se llenan con el virus mientras que lo de una vacunada están libre de la enfermedad
15 JULIO
13 JULIO
Estudio publicado en Nature, que consideró más de dos millones de personas, destacó varios genes asociados a algunos cánceres cómo un predictor para saber si tendrá una versión grave de la enfermedad.
Más de 3.000 científicos de 265 países identifican 13 genes que pueden predecir si padecerá una forma grave de Covid
Lo más leído
1.
2.
3.
4.
5.
Casi nadie tiene claro qué es un modelo generativo. El resto lo leyó en La Tercera
Plan Digital + LT Beneficios$6.990 al mes SUSCRÍBETE